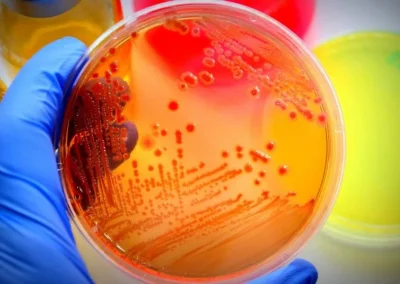

Esperamos con interés escuchar de usted
Oficina central Dirección
| Inspección: | +51 6524650 / Anexo 4651 |
| Análisis: | |
| • Aguas y Alimentos | +51 6524650 / Anexo 4669 |
| • Minerales | +51 6524650 / Anexo 4670 |
Enviar mensaje
Nuestra ubicación
Sitios web internacionales de Alex Stewart
Nuestras localizaciones
Una red global
● Inspecciones ASI, Operaciones de Carga y Descarga
● Laboratorio ASI, Preparación de Muestras y Atención al Cliente
● Sede empresarial del gobierno de ASi